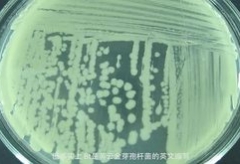

視頻科普:【軍武次位面】——奧運(yùn)角斗場(chǎng)
科普集結(jié)號(hào)
觀看次數(shù):1155

視頻科普:【軍武次位面】——核武之力
科普集結(jié)號(hào)
觀看次數(shù):1119

視頻科普:無(wú)線路由器的輻射可怕么?
科普集結(jié)號(hào)
觀看次數(shù):1091

視頻科普:這些妙招真的能鑒別地溝油嗎?
科普集結(jié)號(hào)
觀看次數(shù):1004
視頻科普:轉(zhuǎn)基因究竟安全不安全?
科普集結(jié)號(hào)
觀看次數(shù):980

視頻科普:【軍武次位面】——王者之虎
科普集結(jié)號(hào)
觀看次數(shù):1115

視頻科普:【軍武次位面】——左輪之魂
科普集結(jié)號(hào)
觀看次數(shù):1025

視頻科普:【軍武次位面】——帝國(guó)時(shí)代
科普集結(jié)號(hào)
觀看次數(shù):1018

視頻科普:【軍武次位面】——搶灘登陸
科普集結(jié)號(hào)
觀看次數(shù):1174

視頻科普:【軍武次位面】——蛟龍潛海4 核平之舟
科普集結(jié)號(hào)
觀看次數(shù):1250

太空科普視頻:天問
科普中國(guó)
觀看次數(shù):1415

視頻科普:致癌肉背后的真相
科普集結(jié)號(hào)
觀看次數(shù):1089

視頻科普:手機(jī)觸摸屏的秘密在哪里?
科普集結(jié)號(hào)
觀看次數(shù):1178

視頻科普:高速磁懸浮列車實(shí)用么?
科普集結(jié)號(hào)
觀看次數(shù):1220

視頻科普:【軍武次位面】——中國(guó)兵器秀2龍之甲
科普集結(jié)號(hào)
觀看次數(shù):1222

視頻科普:【軍武次位面】——紅茶坦克歷險(xiǎn)記
科普集結(jié)號(hào)
觀看次數(shù):1155
 會(huì)員登錄
會(huì)員登錄



















